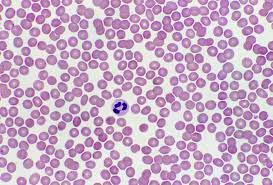
¿A que trastornos se asocia la leucopenia?

Un conteo disminuido de leucocitos en la sangre, conocido como leucopenia, es un hallazgo clínico significativo que se asocia con una serie de condiciones médicas y tratamientos. Esta disminución en el número de glóbulos blancos, que son fundamentales en la defensa del cuerpo contra infecciones y enfermedades, puede tener múltiples causas y consecuencias.
- Radiación y quimioterapia: Uno de los efectos secundarios comunes de la radioterapia y la quimioterapia, que son tratamientos contra el cáncer, es la supresión del sistema inmunológico. Estos tratamientos están diseñados para eliminar células en rápido crecimiento, como las células cancerosas, pero también pueden dañar las células normales en la médula ósea, donde se producen los glóbulos blancos. Como resultado, la leucopenia es una complicación frecuente en pacientes sometidos a estos tratamientos, lo que aumenta su susceptibilidad a infecciones.
- Enfermedades autoinmunitarias: En algunas enfermedades autoinmunitarias, como el lupus eritematoso sistémico y la artritis reumatoide, el sistema inmunológico se vuelve hiperactivo y ataca las propias células y tejidos del cuerpo. Estas enfermedades a menudo se tratan con medicamentos inmunosupresores para frenar la respuesta inmunológica. Sin embargo, estos fármacos pueden disminuir la producción de glóbulos blancos, lo que conduce a la leucopenia.
- Enfermedades de la médula ósea: La médula ósea es el sitio de producción de las células sanguíneas, incluidos los glóbulos blancos. En condiciones como la anemia aplásica, la médula ósea no funciona correctamente y no produce suficientes células sanguíneas, lo que incluye los glóbulos blancos. Esto resulta en leucopenia y una mayor vulnerabilidad a infecciones.
- Uso de fármacos específicos: Algunos medicamentos, como ciertos antipsicóticos, antiepilépticos y otros, pueden tener como efecto secundario la disminución de la producción de glóbulos blancos en la médula ósea, lo que lleva a la leucopenia. Esto es especialmente relevante en pacientes que toman estos medicamentos a largo plazo.
- SIDA: El síndrome de inmunodeficiencia adquirida (SIDA) es una enfermedad causada por el virus de la inmunodeficiencia humana (VIH), que ataca el sistema inmunológico. La infección por VIH puede resultar en una disminución progresiva de los glóbulos blancos, incluidos los linfocitos T CD4, que son una parte fundamental del sistema inmunológico. A medida que disminuye la cantidad de linfocitos T CD4, el sistema inmunológico se debilita, lo que aumenta el riesgo de infecciones en personas con VIH/SIDA.
La leucopenia es una preocupación médica importante, ya que una deficiencia en la cantidad de glóbulos blancos puede debilitar significativamente la capacidad del cuerpo para combatir infecciones. Los pacientes con leucopenia pueden ser más susceptibles a enfermedades y requerir un monitoreo y tratamiento cuidadoso para prevenir infecciones graves. La identificación de la causa subyacente de la leucopenia es esencial para su manejo y tratamiento adecuados.